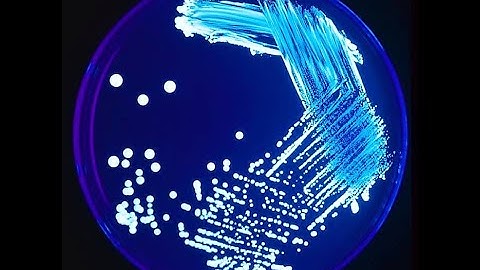
Lucknow University|| B.Sc. Biology(NEP) Sem-1|| Botany Practical File || Microbiology || Part-4

⬇ DOWNLOAD NOW
Kalau muncul iklan pop-up, tutup lalu klik tombol kembali
Download lagu Lucknow University|| B.Sc. Biology(NEP) Sem-1|| Botany Practical File || Microbiology || Part-3 secara gratis hanya untuk keperluan promosi. Dukung artis favorit kamu dengan membeli musik original di iTunes atau platform resmi lainnya.
 Lucknow University|| B.Sc. Biology(NEP) Sem-1|| Botany Practical File || Microbiology || Part-1
Lucknow University|| B.Sc. Biology(NEP) Sem-1|| Botany Practical File || Microbiology || Part-1
 Lucknow University|| B.Sc. Biology(NEP) Sem-1|| Botany Practical File || Microbiology || Part-2
Lucknow University|| B.Sc. Biology(NEP) Sem-1|| Botany Practical File || Microbiology || Part-2
 Lucknow University|| B.Sc. Biology(NEP) Sem-1|| Botany Practical File || Algae || Part-1
Lucknow University|| B.Sc. Biology(NEP) Sem-1|| Botany Practical File || Algae || Part-1
 Lucknow University|| B.Sc. Biology(NEP) Sem-1|| Botany Practical File || Fungi || Part-1
Lucknow University|| B.Sc. Biology(NEP) Sem-1|| Botany Practical File || Fungi || Part-1
 Lucknow University|| B.Sc. Biology(NEP) Sem-1|| Botany Practical File || Algae || Part-2
Lucknow University|| B.Sc. Biology(NEP) Sem-1|| Botany Practical File || Algae || Part-2
Lucknow University|| B.Sc. Biology(NEP) Sem-1|| Botany Practical File || Microbiology || Part-4
Lucknow University|| B.Sc. Biology(NEP) Sem-1|| Botany Practical File || Microbiology || Part-4
 University of Lucknow 🎓❤️
University of Lucknow 🎓❤️
 Lucknow University|| B.Sc. Biology(NEP) Sem-1|| Botany Practical File || Microbiology || Part-5
Lucknow University|| B.Sc. Biology(NEP) Sem-1|| Botany Practical File || Microbiology || Part-5